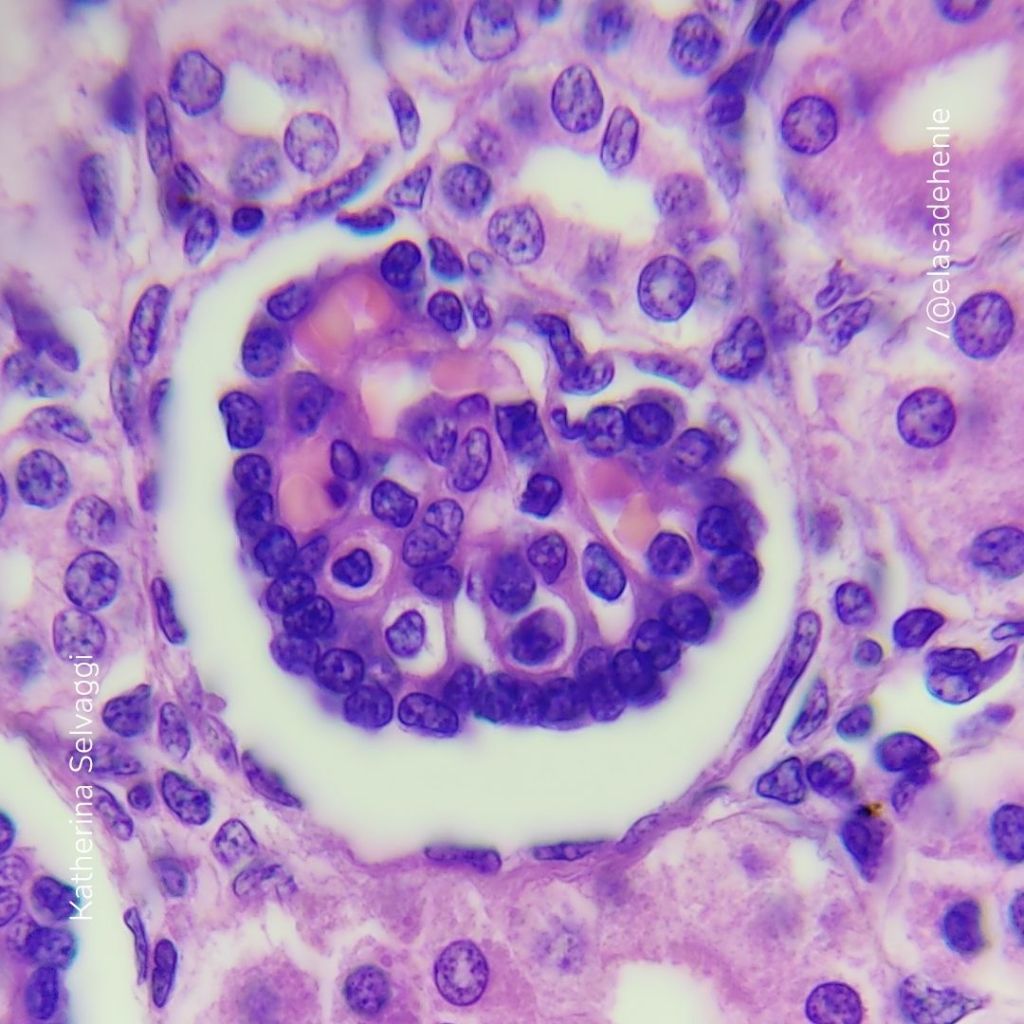

Bienvenidos a mi portafolio, un espacio donde comparto mi experiencia y trayectoria en el campo de la histotecnología.
Inmunohistoquímica
Riñón. SMA.
Hospital de Clínicas

Hematoxilina y eosina
Trompa de Falopio.
COMECA

Alcian Blue
Intestino
EUTM

Feulgen
Cromosomas mitóticos.
Proyecto independiente

Desgaste
Hueso seco.
Proyecto independiente

Hematoxilina y eosina
Intestino.
COMECA

Hematoxilina y eosina
Intestino delgado
Hospital de Clínicas

Hematoxilina y eosina
Trompa de Falopio
COMECA

Alcian Blue – PAS
Intestino delgado
Hospital de Clínicas

Hematoxilina y eosina
Riñón
Hospital Saint Bois
Orceína
Cromosomas mitóticos
Proyecto independiente

PAS – H
Intestino delgado
Hospital de Clínicas

Hematoxilina y eosina
Lipoma
COMECA

PAS – H
Hígado
Hospital de Clínicas

PAP
Citología cérvico – vaginal
Instituto Nacional del Cáncer

Perls
Hígado
EUTM

Azul de toluidina
Corte semifino 200 nm
IIBCE

Hematoxilina y eosina
Piel
COMECA

Corte en parafina
Vesícula biliar
COMECA

Hematoxilina y eosina
Vesícula biliar
COMECA

Sudán III
Persea americana
Proyecto independiente

Hematoxilina y eosina
Trompa de Falopio
COMECA

Hematoxilina y eosina
Vesícula biliar
COMECA

Bloques
Inclusión en parafina
Hospital Evangélico

Hematoxilina y eosina
Cordón umbilical
Laboratorio Dra. C. Álvarez

Material fijado en FAA
Esporangios de Helecho
Proyecto independiente

Esclereidas
Pyrus communis
Proyecto independiente

Papanicolaou
Citología cérvico – vaginal
Hospital Evangélico

IPA
Taller de técnicas histológicas dirigido a docentes

ANDE – ANII
Taller de técnicas histológicas financiado (VIN 2023).

ANDE – ANII
Taller de técnicas histológicas financiado (VIN 2023).

ANDE – ANII
Taller de técnicas histológicas financiado (VIN 2023).

Neuritas
Juego educativo
Proyecto independiente

Kits educativos
Kits para implementar técnicas histológicas en el aula

Glicerina – Gelatina
Medio de montaje
Proyecto independiente

Taller
Taller de técnicas histológicas
Preparados permanentes.

Kombucha
Levaduras y bacterias
Proyecto independiente

Kits educativos
Técnicas histológicas en el aula
Proyecto independiente

Neuritas
Juego educativo
Proyecto independiente

Safranina
Diafanizado de hoja
Proyecto independiente

Corte en parafina
Músculo esquelético
IIBCE

Teasing
Fibras musculares
IIBCE

Levaduras
Saccharomyces cerevisiae
Proyecto independiente

Safranina
Tallo
Proyecto independiente

Anabaena azollae
Preparado fresco
Proyecto independiente

Nostoc sp.
Preparado fresco
Proyecto independiente

Escama peltada
Olea europaea L.
Proyecto independiente

«Preparados» MEB
Microscopía electrónica
IIBCE

Corte en parafina
Baño de flotación
COMECA

Hematoxilina y eosina
Cerebelo
Proyecto independiente

Hematoxilina y eosina
Neuronas de Purkinje
Proyecto independiente

Microtomía
Obtención de cortes seriados
Hospital de Clínicas

Bloques tallados
Inclusión en parafina
Hospital de Clínicas

Safranina
Estoma – Epidermis foliar
Proyecto independiente

Bacterias
Yogur
Proyecto independiente

Anabaena azollae
Cavidad foliar de Azolla
Proyecto independiente

Cloroplastos
Elodea
Proyecto independiente

Bloques de Epon – MET
Microscopía electrónica
IIBCE

Hematoxilina
Cromosomas mitóticos
Proyecto independiente

Desgaste
Conducto de Volkmann
Proyecto independiente

Soy Histotecnóloga, con sólidos conocimientos y habilidades en el procesamiento e inclusión de material biológico, corte, coloración de rutina, técnicas especiales e inmunohistoquímica.
Mi enfoque me permite abordar la histotecnología de manera integral, adaptando y perfeccionando técnicas para garantizar precisión y calidad en cada resultado.
Aquí encontrarás una muestra de mi trabajo en Histotecnología, en laboratorios, docencia, investigación y divulgación científica.
contacto: kathselvaggi@gmail.com